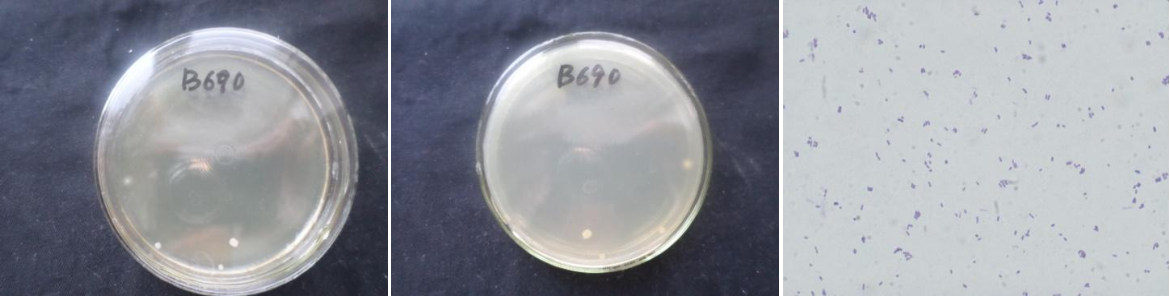

Loading...
| StrainNO | B690 |
| Classification | Halomonas |
| 16s rDNA sequence | ACATGCAGTCGAGCGGCAGCACGGGGAGCTTGCTCCCTGGTGGCGAGCGGCGGACGGGTGAGTAATGCATAGGAATCTGCCCGG TAGTGGGGGATAACCTGGGGAAACCCAGGCTAATACCGCATACGTCCTACGGGAGAAAGCAGGGGCTCTTTGGACCTTGCGCTA TCGGATGAGCCTATGTCGGATTAGCTGGTTGGTGAGGTAATGGCTCACCAAGGCGACGATCCGTAGCTGGTCTGAGAGGATGAT CAGCCACATCGGGACTGAGACACGGCCCGAACTCCTACGGGAGGCAGCAGTGGGGAATATTGGACAATGGGCGCAAGCCTGATC CAGCCATGCCGCGTGTGTGAAGAAGGCCCTCGGGTTGTAAAGCACTTTCAGTGGGGAAGAAAGCCTGGCGGTTAATACCCGCCA GGAAGGACATCACCCACAGAAGAAGCACCGGCTAACTCCGTGCCAGCAGCCGCGGTAATACGGAGGGTGCGAGCGTTAATCGGA ATTACTGGGCGTAAAGCGCGCGTAGGCGGCTTGATAAGCCGGTTGTGAAAGCCCCGGGCTCAACCTGGGAATGGCATCCGGAAC TGTCAGGCTAGAGTGCAGGAGAGGAAGGTAGAATTCCCGGTGTAGCGGTGAAATGCGTAGAGATCGGGAGGAATACCAGTGGCG AAGGCGGCCTTCTGGACTGACACTGACGCTGAGGTGCGAAAGCGTGGGTAGCAAACAGGATTAGATACCCTGGTAGTCCACGCC GTAAACGATGTCGACTAGCCGTTGGGTCCTTCGCGGACTTTGTGGCGCAGTTAACGCGATAAGTCGACCGCCTGGGGAGTACGG CCGCAAGGTTAAAACTCAAATGAATTGACGGGGGCCCGCACAAGCGGTGGAGCATGTGGTTTAATTCGATGCAACGCGAAGAAC CTTACCTACCCTTGACATCCTGCGAACCCTTCGGAGACGAAGGGGTGCCTTCGGGAGCGCAGTGACAGGTGCTGCATGGCTGTC GTCAGCTCGTGTTGTGAAATGTTGGGTTAAGTCCCGTAACGAGCGCAACCCTTGTCCCTATTTGCCAGCGATTCGGTCGGGAAC TCTAGGGAGACTGCCGGTGACAAACCGGAGGAAGGTGGGGACGACGTCAAGTCATCATGGCCCTTACGGGTAGGGCTACACACG TGCTACAATGGTTGGTACAAAGGGTTGCGAGCTCGCGAGAGCAAGCCAATCCCAGAAAGCCGATCTCAGTCCGGATCGGAGTCT GCAACTCGACTCCGTGAAGTCGGAATCGCTAGTAATCGTGAATCAGAATGTCACGGTGAATACGTTCCCGGGCCTTGTACACAC CGCCCGTCACACCATGGGAGTGGACTGCACCAGAAGTGGTTAGCCTAACCTTCGGGAGGGCGATCACCACGGTGTGGTTCATGA CTGGGGTGAAGT |
| Strain Morphology Photos | |
| Morphological Description | Colony round;clam white;edge neatly;steam bun shaped;slippy;sticky;Wax Sample;Bacteriophage Rod-shaped;no spore |